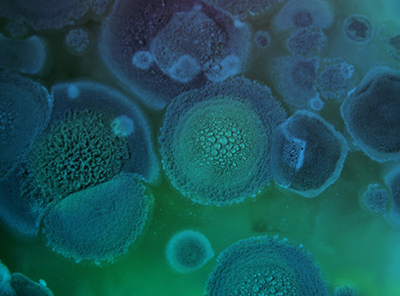

CEF Cell Media

細(xì)胞培養(yǎng)產(chǎn)品
科學(xué)與基礎(chǔ)研究 細(xì)胞培養(yǎng)相關(guān)試劑 疫苗與生物制藥 細(xì)胞與基因治療 血清 酶及殘留檢測(cè)試劑盒微生物培養(yǎng)產(chǎn)品
預(yù)灌裝平皿培養(yǎng)基 瓶裝成品培養(yǎng)基 模擬灌裝培養(yǎng)基個(gè)性化服務(wù)
個(gè)性化服務(wù)概述 培養(yǎng)基定制 細(xì)胞馴化資料下載
產(chǎn)品目錄冊(cè) 產(chǎn)品使用手冊(cè) 質(zhì)檢報(bào)告 安全技術(shù)說(shuō)明書(shū) 引用和參考文獻(xiàn) 產(chǎn)品配方表 友商產(chǎn)品參照對(duì)比表關(guān)于源培
公司介紹 資質(zhì)證書(shū) 知識(shí)產(chǎn)權(quán) 公司新聞 專(zhuān)項(xiàng)活動(dòng) 禮品展示 銷(xiāo)售條款聯(lián)系我們
產(chǎn)品咨詢(xún) 在線(xiàn)留言 授權(quán)代理商 公司地址服務(wù)電話(huà):
021-37196939

服務(wù)電話(huà):021-37196939
服務(wù)郵箱:info@basalmedia.com
地址:上海市奉賢區(qū)嵐豐路1569號(hào)
ICP備:滬ICP備18017157號(hào)-1
